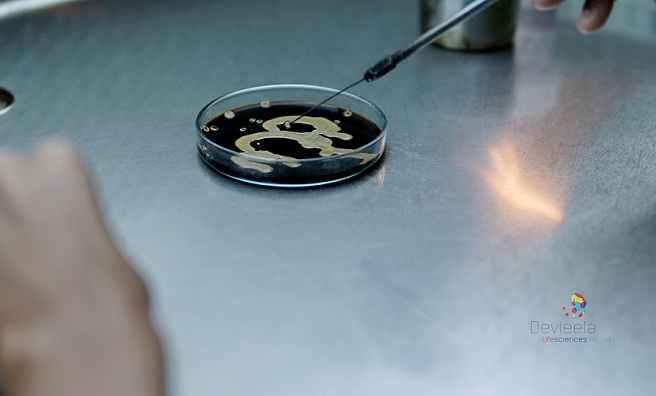
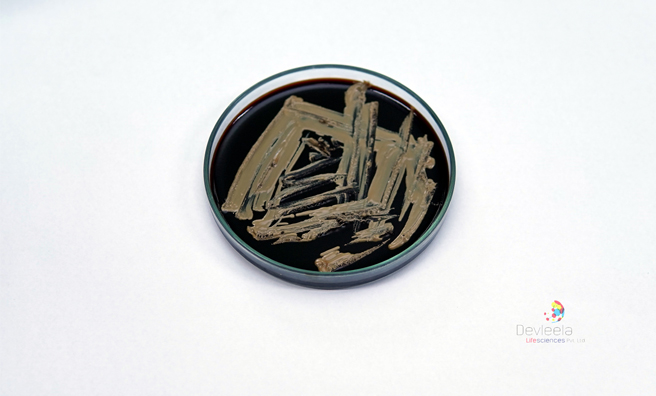

Overview
Devleela Lifesciences Pvt. Ltd. was established in 2013 under Devleela Group to augment Research and Development activities in the field of microbial biotechnology and related areas. The company is recognized by the Department of Scientific and Industrial Research (DSIR), Ministry of Science & Technology, Government of India.